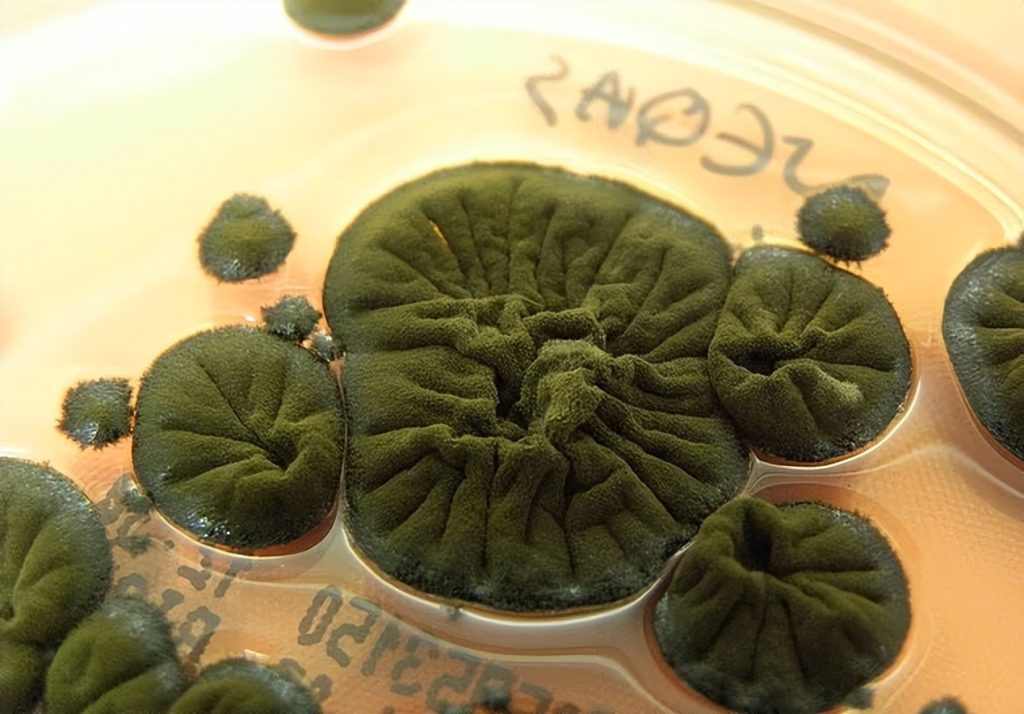

快40年过去,切尔诺贝利核灾的废墟里竟然出现了一个颠覆认知的生命现象:一种叫球形枝孢霉(Cladosporium sphaerospermum)的黑色真菌,不仅能在高辐射环境下活得好好的,还能“吃”辐射长得更快。科学家发现,它甚至会主动朝辐射源伸展,就像在“追光”,只不过这里的光是致命的伽马射线。
研究显示,这种真菌的秘密武器可能是黑色素。我们皮肤里的黑色素能防紫外线,而这种真菌的黑色素似乎能把伽马射线转化成化学能,类似植物的光合作用,只不过它做的是“辐射合成”。NASA已经盯上它,计划用这种真菌做成“生物砖”,未来在月球或火星建基地时,用它来抵御宇宙辐射,比传统的铅板轻得多,还能自我修复。国际空间站的实验更是让人震惊:在太空辐射下,这种真菌生长速度提升了21倍,还能有效阻挡辐射穿透。
这不仅是科幻感爆棚的发现,更可能改变核废料处理和癌症防治的未来。切尔诺贝利的狼群也在悄悄进化,科学家检测到它们的基因出现抗癌相关的突变,或许能为人类找到降低癌症风险的线索。连那里的树蛙都变黑了,黑色素不仅让它们更抗辐射,还能把这种能力传给下一代。
看到这些,我真的觉得生命的韧性超乎想象。人类总觉得自己是地球的主角,但在核灾废墟里,另一种生命却在用自己的方式重写生存规则。它们没有选择,却在极端环境中找到能量来源,甚至可能成为我们未来的“保护伞”。这让我反思,我们在追求科技和探索宇宙的过程中,是否也该学会像这些真菌一样,拥抱变化、寻找突破,而不是一味内卷和焦虑。
如果这种真菌真的能帮我们建太空基地、清理核污染,甚至降低癌症风险,那未来的生物科技将不再只是实验室里的冷冰冰数据,而是和人类生存息息相关的“硬核伙伴”。问题是,我们能否在利用它的同时,保持对自然的敬畏?毕竟,切尔诺贝利的故事提醒我们,科技失控的代价有多惨烈。
你觉得,如果NASA真的用这种真菌造月球基地,人类会不会迎来一个“生物建筑时代”?还是说,这背后还有我们没想到的风险?